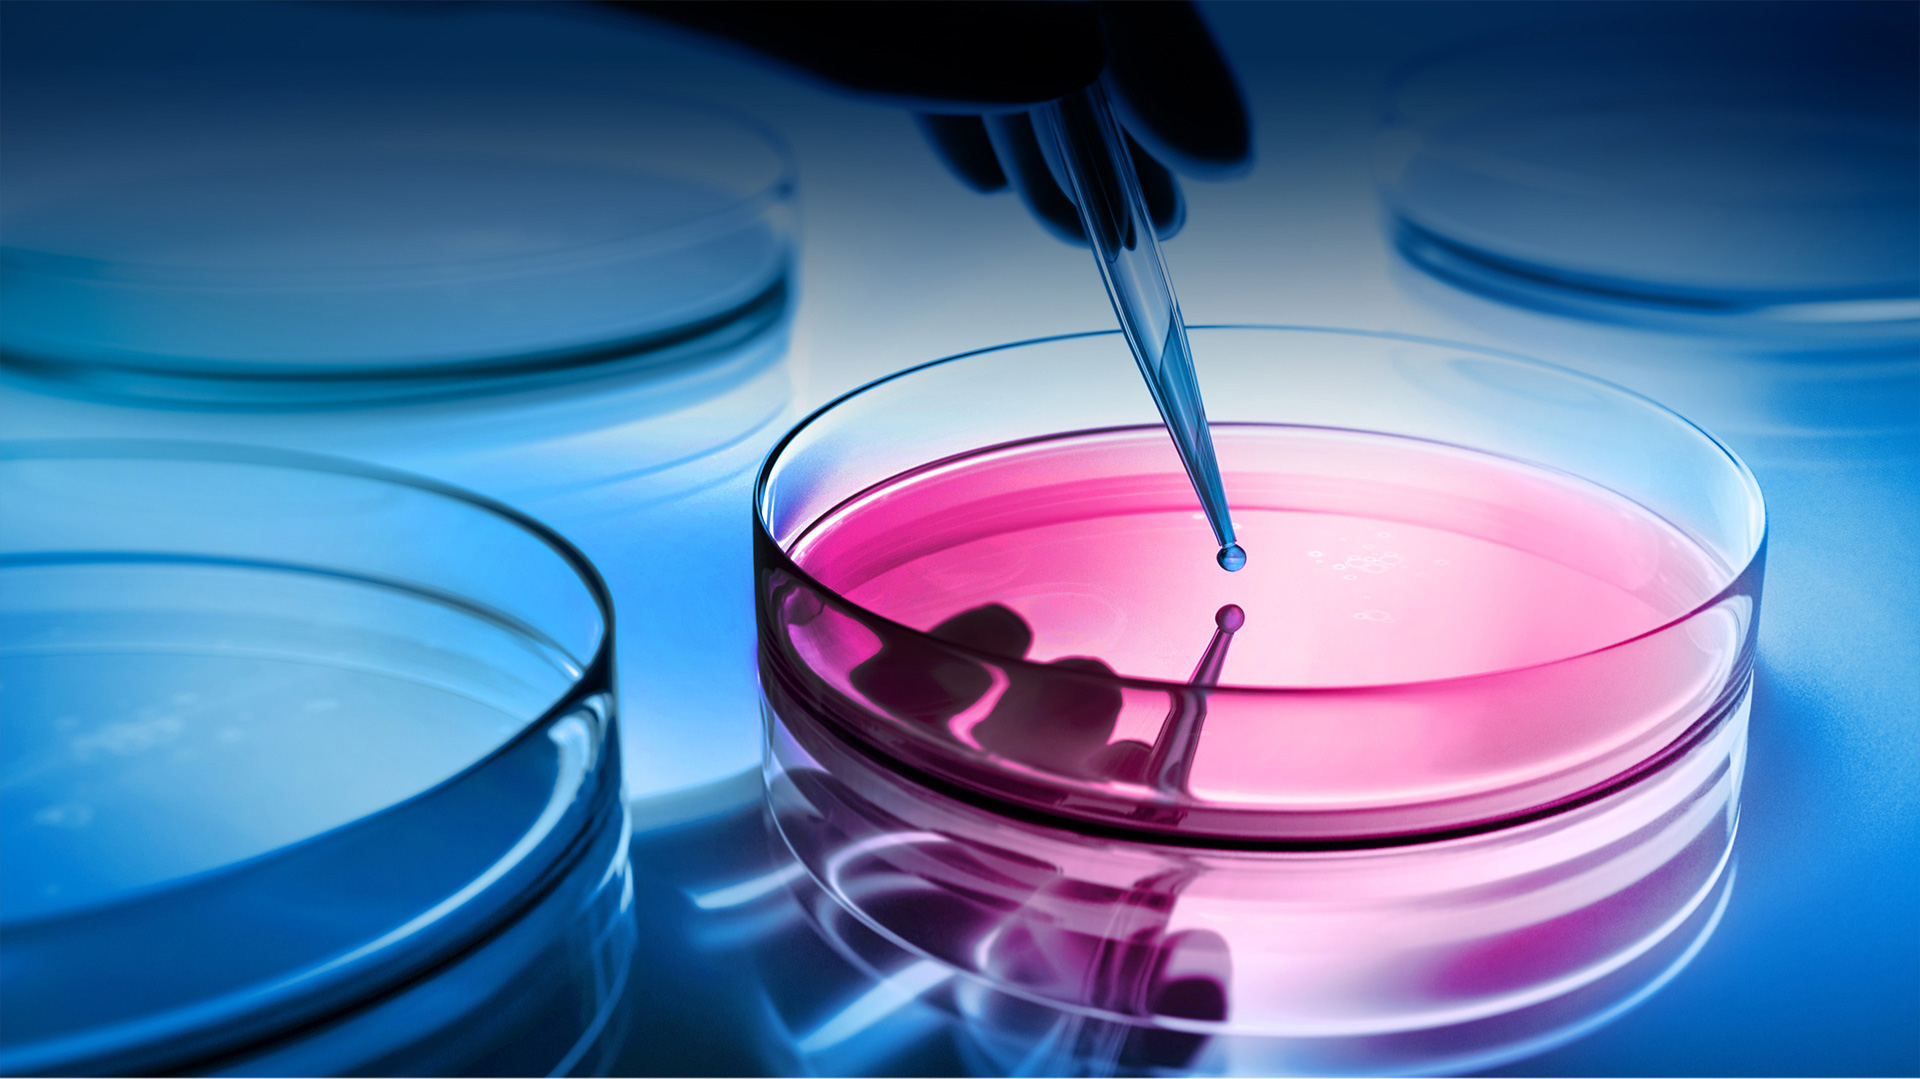
배너1

메인슬라이드
동국제약
Our Passion Your Health
우리에게 가장 중요한 것은 고객의 건강하고 행복한 삶입니다.
고객을 향한 변치 않는 우리이 열정으로 더 건강한 내일을 만들어 갑니다.
Since 1968
50주년 기념관
‘Human & Life’라는 기업이념 아래 지난 50년간
생명 존중 및 건강한 국민생활 추구를 위해 걸어온 동국의 발자취

연구개발
연구 개발에 대한 끊임없는 열정으로
새로운 가치, 차별화된 제품 개발을 추구하고 있습니다.
'사람중심의 연구개발'이라는 R&D slogan 하에 동국의 고유성을 부여할 수 있는 글로벌 수준의 연구역량을 보유한 R&D Center로 성장하기 위한 노력을 지속하고 있습니다.

50주년 기념관
50주년 기념관
'HUMAN & LIFE'라는 기념 이념 아래 지난 50년간 생명 존중 및 건강한 국민생활 추구를 위해 걸어온 동국의 발자취
-
1989.05
중앙연구소 설립
-
1999.12
백만불 수출탑 수상
-
2005.11
인사돌 플러스
2005올해의 브랜드 대상
-
2017.12
한국 소비자 만족도
평가 대상(KCSGE)
자세히보기